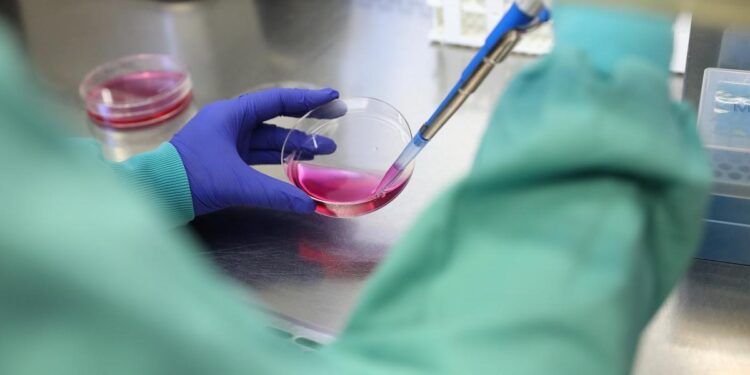
Primer estudio sobre populismo científico en España: un 3,6% de los ciudadanos desconfía de la ciencia y de la comunidad científica

El presidente argentino Javier Milei ha cargado más de una vez contra lo que según él es la “casta de científicos e intelectuales que creen que por tener una titulación académica sus opiniones son más válidas que las del resto” y, de paso, ha defendido que el cambio climático no existe sino que es “puro marxismo cultural”. En la misma línea, Donald Trump también lleva años utilizado su altavoz para cuestionar hechos científicos contrastados como el avance del calentamiento global o incluso para desacreditar la opinión de expertos y decir, por ejemplo, que la mejor manera de combatir el covid era inyectarse desinfectante. Estos planteamientos erróneos se conocen como populismo científico y, según desvela el primer estudio realizado sobre este fenómeno en España, actualmente ya convence a un 3,6% de los ciudadanos. “La mayoría de la población española confía en la ciencia y en los científicos pero hay un grupo que está en los niveles máximos de desconfianza”, afirma Celia Díaz Catalán, investigadora de la Universidad Complutense de Madrid y codirectora científica del estudio.
La encuesta, impulsada por la Fundación Española para la Ciencia y la Tecnología (FECYT), recoge la opinión de 987 personas mayores de 18 años residentes en España. Durante la entrevista, los participantes tuvieron que responder a una serie de preguntas sobre, por ejemplo, su consumo de información científica, su opinión en cuanto a la utilidad de la ciencia y, en general, su visión sobre el uso de la ciencia en diferentes ámbitos de la sociedad y la política.
El análisis de los datos recogidos en esta encuesta mostró que el 3,6% de la población española se encuentra en estos momentos en niveles extremos de populismo científico y, por lo tanto, afirma desconfiar radicalmente de la ciencia, de los científicos y de sus resultados. Este fenómeno se observó tanto entre hombres y mujeres, así como en distintas franjas de edad y hasta en personas con distintas ideologías políticas.
La encuesta desvela que los postulados populistas son más comunes entre las personas con un nivel educativo bajo
No hay un perfil único de persona que simpatiza con estas ideas populistas ya que cualquier persona, en mayor o menor medida, puede acabar comulgando con estas ideas pero, según apunta este primer estudio sobre la materia, al menos en España se ha visto que las personas con nivel educativo más bajo y que menos saben sobre ciencia también son las que más desconfían sobre sus resultados y sobre los científicos que hay detrás de estos trabajos. Uno de los resultados más sorprendentes de este estudio es que, contrariamente a lo que se podría pensar, un gran número de personas radicalizadas en cuestiones de populismo científico afirman tener un alto interés en la ciencia y en su divulgación por lo que, tal y como señalan los expertos, ‘el populismo científico no es una cuestión de desinterés, sino de desconfianza en las supuestas élites’.
Negacionismo y teorías de la conspiración
En la literatura académica muchas veces se dice que el populismo científico es el escalón previo a postulados mucho más radicales dentro del negacionismo y de las teorías de la conspiración. En esta encuesta, por ejemplo, se señala que los españoles con mayores niveles de populismo científico también son los que tienden a mostrar mayor escepticismo sobre el cambio climático y a desconfiar más de los científicos que trabajan en este campo. De la misma manera, las personas más radicalizadas dentro del populismo científico muestran una mayor inclinación a creer en teorías conspirativas sobre las vacunas y a apoyar ideas como que, por ejemplo, los científicos y las farmacéuticas trabajan con intereses ocultos.
Los perfiles más alineados con el populismo climático y la desconfianza hacia la ciencia también son más proclives a no creer en el cambio climático o en las vacunas
Según han explicado los autores de este trabajo en una presentación realizada con el Science Media Centre España (SMC), aunque el avance del populismo científico en España sea razón de preocupación, sobre todo por su relación con ciertos grupos políticos ultra, cabe recordar que la mayoría de la población española confía tanto en las instituciones científicas como en sus resultados. Los datos demuestran que la gran mayoría de la población española afirma que debería destinarse más dinero a la investigación científica, más de la mitad defiende que los resultados de la ciencia benefician mucho a la sociedad y una gran mayoría muestra un gran apoyo a diferentes medidas contra el cambio climático.
‘Desde la investigación y su comunicación deberíamos hacer un esfuerzo por ser más transparentes y escuchar y comprender las opiniones y preocupaciones de la gente’
“Una mayoría de personas está de acuerdo con que la investigación tiene un papel muy relevante que jugar en nuestra sociedad, pero en cierto modo se sienten excluidas. Piensan que la investigación no aborda temas que son importantes para ellos y consideran que los científicos no tienen en cuenta otras opiniones’, afirma Cintia Refojo, responsable de la Unidad para el Avance de la Comunicación Científica de FECYT y una de las coordinadoras del estudio. “Desde la investigación y su comunicación deberíamos hacer un esfuerzo por ser más transparentes y escuchar y comprender las opiniones y preocupaciones de la gente. La ciencia no se rige por el principio de autoridad, no deberíamos esperar un apoyo basado en ella”, comenta esta especialista.